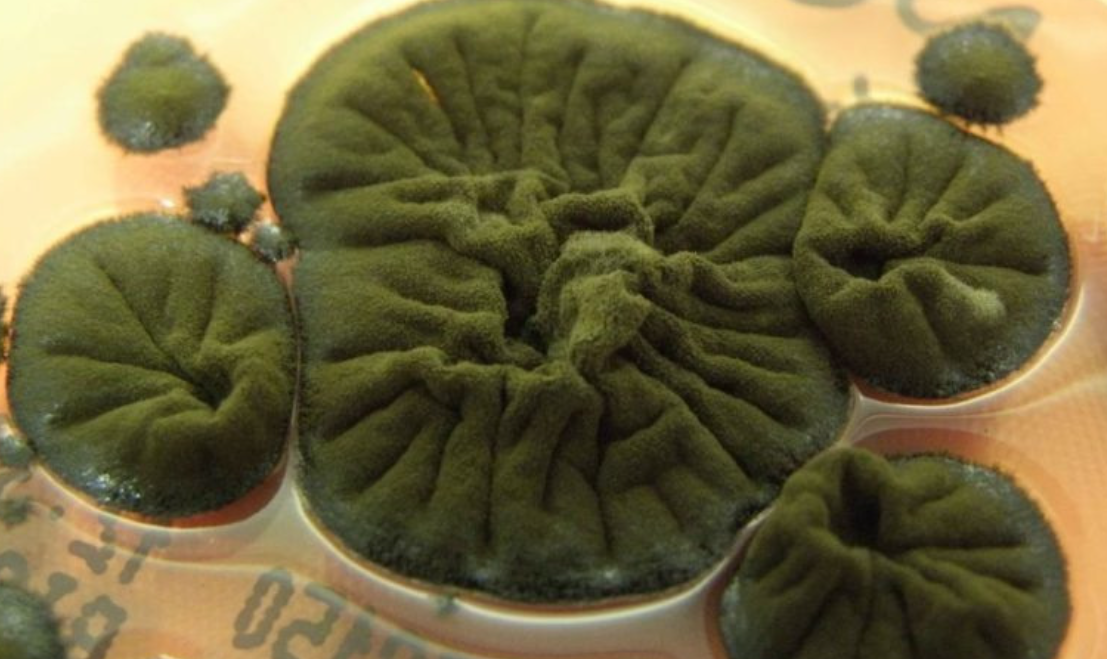
切尔诺贝利废墟发现耐辐射真菌 或开启“辐射合成”与太空防护新路径

切尔诺贝利核电站事故过去近40年,其隔离区虽禁止人类进入,却成了多种生物的栖息地。其中,一种名为球孢枝孢菌的黑色真菌在损毁反应堆废墟中存活下来,展现出非凡的生存能力。该废墟是地球上放射性最强的建筑物之一,球孢枝孢菌却能在此扎根。
研究发现,球孢枝孢菌不仅能抵抗电离辐射,在电离辐射环境下生长得更好。科学家推测,其体内黑色素可能使其通过类似植物光合作用的机制利用电离辐射能量,即“辐射合成”。这一假想过程最早于2008年提出,黑色素功能类似叶绿素,能吸收辐射并转化为化学能,同时保护细胞免受辐射损害。不过,这一假说虽前景可观,但至今未找到放射合成的直接证据,也未证明电离辐射能直接导致碳固定或提供明确代谢益处。
2022年,国际空间站上的实验为这种真菌增添了新神秘色彩。实验显示,球孢枝孢菌菌落能有效阻挡宇宙辐射,这为其用作太空飞行生物防护罩提供了可能。球孢枝孢菌在对其他生物致命的环境中生存的能力,仍是科学谜题,也表明生命在最极端条件下也能找到生存之道。